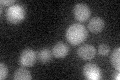
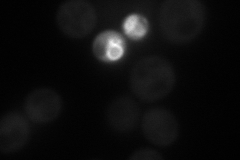
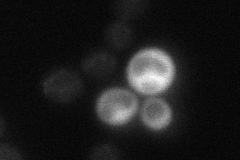
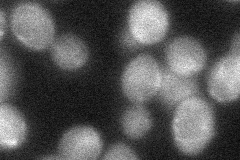

View description
Guanine nucleotide exchange factor (GEF) for Arf proteins; involved in vesicular transport; suppressor of ypt3 mutations; member of the Sec7-domain family
Localization:
Intensity:
Fold change:
Significance:
-
C’ GFP library in SD
below threshold15.82 -
N' NOP1pr-GFP in SD
cytosol41.0008 -
N' TEF2pr-mCherry in SD

cytosol38.0167 -
N' NATIVEpr-GFP in SD
below threshold19.2716 -
N' TEF2pr-VC and Cyto-VN in SD
cytosol36.0294 -
C’ GFP library in SD+DTT

cytosol14.560.92No -
C’ GFP library in SD+H2O2

cytosol17.051.07No -
C’ GFP library in Starvation Media

cytosol17.021.07No -
C’ GFP library on the background of Pup2-DaMP

below threshold -
C’ GFP library on the background of CCT mutant

below threshold16.9791.07265No
